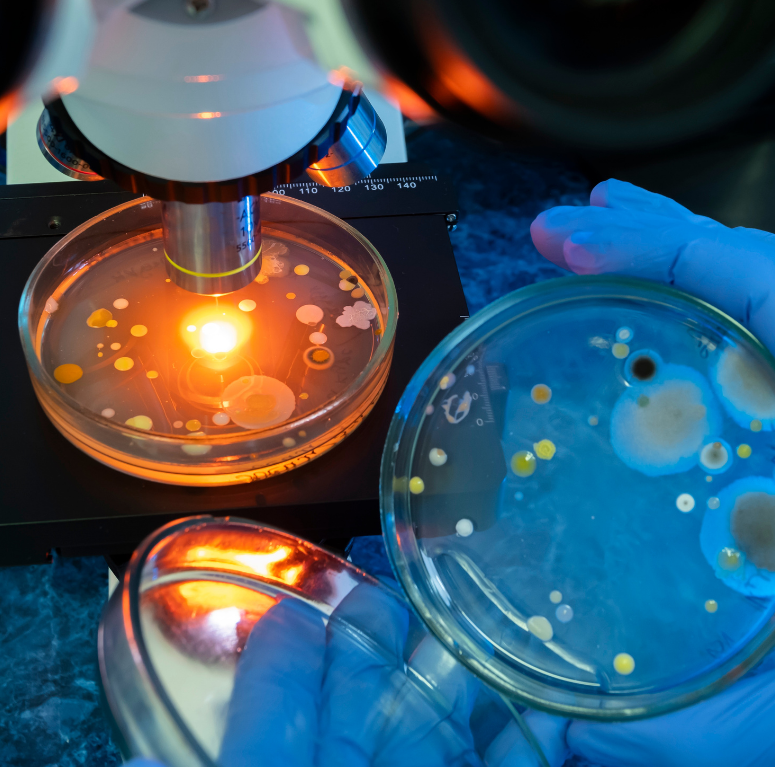
life science, microscopes, optical tweezers and fluorescent spectroscopy

Products

Cryogenics
We offer exceptional consultancy services specifically designed to meet all your cryogenic research needs. Our areas of expertise include:
Dilution refrigerators for quantum measurements and scaling, optical cryostats, cryogenic temperature controls and helium recovery & Liquefaction among others.
We are committed to providing guidance on the most suitable solutions that align with your budgetary constraints and research objectives.
For inquiries on cryogenics equipment and support service, Click here to contact us
Optics
We provide a wide array of optical lenses, beamsplitters and filters designed to meet your specific research needs.
In partnership with industry-leading manufacturers, our team is committed to offering expert guidance and support to address all your optical research requirements.
For inquiries relating to our optical lenses and filters, Contact Us


Spectroscopy
Reach out to us to explore solutions tailored to your spectroscopy research requirements.
We offer a diverse range of spectroscopic research equipment, including spectrometers, CCD, ICCD, X-RAY cameras and 3D confocal Raman microscopy, which can be seamlessly integrated with optical tweezers for sophisticated cell manipulation.
Contact Us to discuss your specific needs
Life Science
When navigating a complex research area such as Life Science, finding the appropriate equipment can be quite challenging.
DIVA Consult provides a diverse range of scientific instruments and research tools, from microscopes to optical tweezers and fluorescent spectroscopy, tailored to meet the unique performance requirements of your research while considering your budget.
Don’t hesitate to reach out to us to discuss your specific needs.
For information relating to life science equipment, Contact Us

Lights & Lasers
Lights and lasers are integral to numerous scientific research and production processes.
At DIVA Consult, we provide an extensive array of lights and lasers tailored to meet your specific research needs.
Our offerings include laser beam diagnostics, laser power measurements, and a variety of light sources for scientific exploration.
We invite you to Contact Us to discuss your lighting and laser requirements in detail.
Material Science
The diverse range of substances in material science adds to the complexity of this research field.
DIVA Consult provides expert guidance on all Material Science equipment, tailored to your specific research needs.
From temperature measurement systems to crystal growth furnaces, microscopes and more, we offer all the tools necessary for your success. Contact Us to discuss your specific requirements.


Magnetism
DIVA Consult offer a variety of magnetism research systems, tailored to meet the specific performance characteristics of your experiments and budget constraints.
From magnetic field measurements to power supply for superconducting magnets, our team is ready to offer expert advice and customised solutions suited to your research needs.
Contact Us now to discuss your needs
Imaging
DIVA Consult offers an extensive array of Imaging and X-Ray Analysis Systems designed to enhance your research endeavors.
Whether you require VIS-X-Ray Cameras & Detectors or Thermography Cameras, we are committed to assisting you in selecting the optimal equipment that meets the specific needs of your laboratory setup.
For information relating to your imaging setup, Contact Us

